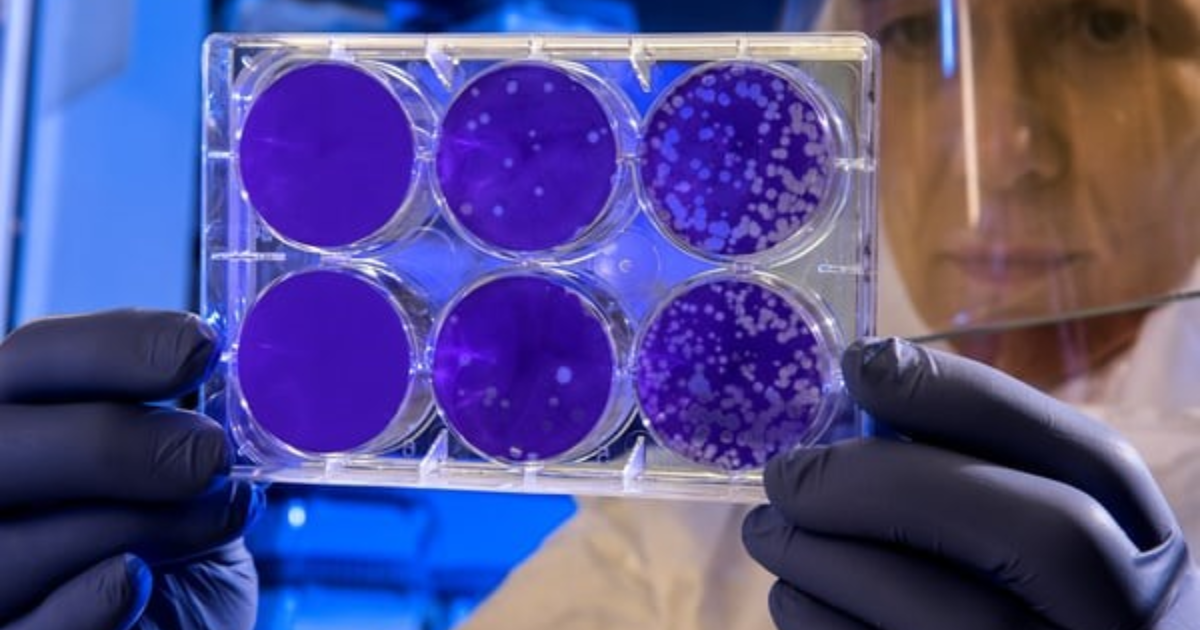
Un scientifique qui tient des récipients avec des enzymes

Des chercheurs de l’Université d’Ottawa s’affairent à améliorer les méthodologies d’ingénierie enzymatique – et leurs conclusions viennent d’être publiées dans la revue scientifique Nature Communications.
Les enzymes ont de nombreuses applications industrielles et biotechnologiques. Leurs nombreuses vertus en font les catalyseurs les plus efficaces qui soient; ils peuvent même accélérer par plus d’un milliard de fois la vitesse des réactions chimiques. Mais comme les activités enzymatiques d’origine naturelle sont limitées, leurs applications le sont également. Si des chercheurs sont parvenus à créer des enzymes artificielles, celles-ci n’ont toutefois pas l’efficacité catalytique de leurs pendants naturels.
Nous avons discuté avec Roberto Chica, auteur principal et professeur titulaire au Département de chimie et sciences biomoléculaires de l’Université d’Ottawa, pour mieux comprendre les conclusions de l’étude.
Parlez-nous un peu des enzymes artificielles.
Ces 20 dernières années, des chercheurs ont réussi à créer de toutes pièces des enzymes artificielles destinées à différentes transformations organiques types. Ils y sont parvenus grâce à des techniques de conception assistée par ordinateur, qui consistent à construire un site catalytique sur un échafaudage protéique dénué de l’activité catalytique recherchée.
La méthode fonctionne, mais on en tire chaque fois des enzymes artificielles aux capacités catalytiques bien inférieures à celles des enzymes naturelles. Il faut donc les soumettre à une « évolution dirigée » pour optimiser leur activité. L’évolution dirigée est un processus qui introduit des mutations aléatoires dans une protéine pour créer une grande banque d’enzymes mutantes, à partir de laquelle on sélectionne les mutations favorables. Cette opération nécessite souvent plusieurs rondes de mutagenèses aléatoires et de sélection pour démultiplier le niveau d’activité des enzymes.
En quoi vos travaux sont-ils liés à l’évolution dirigée?
Nos travaux montrent que l’évolution dirigée permet de multiplier d’environ mille fois l’efficacité catalytique d’un biocatalyseur conçu par ordinateur en modulant l’ensemble d’états structurels qu’il peut adopter afin de favoriser ceux qui ont de meilleures propriétés catalytiques.
Ces observations nous ont permis de créer un biocatalyseur artificiel dont l’efficacité catalytique rivalise avec celle de l’enzyme naturelle moyenne.
Quelle découverte marquante avez-vous faite?
Nous avons conçu une méthode d’ingénierie enzymatique par ordinateur d’une précision inégalée, car elle permet d’estimer la flexibilité intrinsèque de la protéine servant de gabarit.
Pourquoi est-ce important?
Les méthodes utilisées jusqu’à maintenant visaient à créer une structure stable qui ne tient pas compte du dynamisme des enzymes naturelles, une caractéristique pourtant essentielle à leur fonction (pour être de bons catalyseurs, les enzymes doivent « bouger »).
Jusqu’ici, on ignorait s’il était possible de créer par ordinateur une enzyme artificielle aussi efficace qu’une enzyme naturelle sur le plan catalytique. Or, nos travaux montrent qu’on peut le faire, à condition d’utiliser un ensemble structurel de modèles protéiques reproduisant presque exactement leur flexibilité de conformation, contrairement à l’utilisation d’un modèle unique comme par le passé.
Nos conclusions suggèrent que l’utilisation d’un ensemble structurel à l’étape de l’ingénierie par ordinateur pourrait éviter le recours à l’évolution dirigée grâce à l’échantillonnage d’états structurels propices à la catalyse lors de l’étape de la conception.
Quelles sont les applications potentielles de vos travaux?
Si l’on peut créer de toutes pièces des enzymes capables de catalyser efficacement la réaction chimique recherchée, on ouvrira la voie à des biotechnologies extrêmement utiles que les enzymes naturelles n’ont pas permis de générer jusqu’ici.

Qu’aimeriez-vous ajouter?
Les travaux se sont déroulés de 2018 à 2020 à l’Université d’Ottawa et à l’Université de Californie à San Francisco.
L’étude a été signée par la doctorante Rojo V. Rakotoharisoa et l’ancien boursier postdoctoral Aron Broom, tous deux affiliés à l’Université d’Ottawa. Nous avons travaillé en collaboration avec l’équipe de James S. Fraser, au Département de bio-ingénierie et des sciences thérapeutiques de l’Université de Californie à San Francisco.
L’article « Ensemble-based enzyme design can recapitulate the effects of laboratory directed evolution in silico » a récemment été publié dans Nature Communications.
Pour plus d’informations :
Justine Boutet
Agente de relations médias
Cell: 613.762.2908
justine.boutet@uottawa.ca